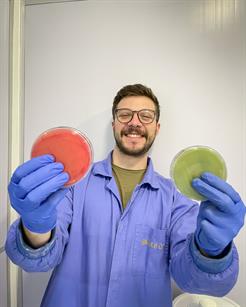

Conquista inédita: doutorando da UPF recebe o Prêmio Pesquisador Gaúcho 2023
24/08/2023
15:23
Por: Assessoria de Imprensa
Fotos: Arquivo pessoal
Mateus Torres Nazari, do Programa de Pós-graduação em Engenharia Civil, foi premiado na categoria Jovem Pesquisador
O incentivo à pesquisa em todas as áreas ocorre de maneira constante na Universidade de Passo Fundo (UPF) por meio de diversas ações junto à comunidade acadêmica. Ao longo de mais de 50 anos de história, a produção científica sempre teve destaque na Instituição, oportunizando o desenvolvimento de novos produtos e metodologias em todas as áreas do conhecimento. Como resultado, nesta semana, a pesquisa desenvolvida pelo doutorando do Programa de Pós-graduação em Engenharia Civil da UPF, Mateus Torres Nazari, foi reconhecida pelo Prêmio Pesquisador Gaúcho 2023, promovido pela Fundação de Amparo à Pesquisa do Rio Grande do Sul (Fapergs).
.jpg)
Com o tema “Ciência e Inovação: alicerces do futuro”, o Prêmio visa a reconhecer o trabalho de pesquisadores e profissionais que se destacaram na academia, nos setores público, industrial, empresarial e na área de comunicação. Nazari foi premiado na categoria Jovem Pesquisador, com a pesquisa denominada Bioprospecção de actinomicetos para fins agrícolas e ambientais. “A pesquisa busca explorar o potencial de um grupo de bactérias (os actinomicetos) para aplicações agrícolas e ambientais. Esses microrganismos são amplamente utilizados pela indústria farmacêutica para a produção de antibióticos. Por outro lado, eles apresentam outras aplicações promissoras, seja no campo agrícola pela sua capacidade de promover crescimento de plantas e/ou controlar pragas e doenças e no viés ambiental para biorremediar ambientes contaminados”, explica.
Interação entre Universidade e empresa
O prêmio incentiva a cultura da inovação nas cadeias produtivas e a integração entre governo, comunidade científica e meio empresarial para a geração de melhorias à sociedade gaúcha. No caso da pesquisa do doutorando, o vínculo é realizado com a empresa Beifiur, que tem sede no município de Garibaldi (RS) e atua com produção de mudas de videira. O estudo é desenvolvido por meio de uma bolsa do Programa MAI/DAI do CNPq.
.jpg)
De acordo com ele, ao final da pesquisa a pretensão é obter dois produtos com potencial comercial. “O primeiro é um promotor de crescimento de plantas (inoculante) a ser utilizado no ramo agrícola como uma alternativa à redução de insumos químicos, colaborando para uma agricultura mais sustentável”, afirma. Já o segundo é um material à base de actinomiceto imobilizado em biocarvão (um biorremediador) capaz de realizar o tratamento de contaminantes presentes na água, no solo e no ar. “Ambos os produtos visam contribuir para solução de problemas reais e crescentes da sociedade, mas que, sobretudo, tem sido pensados e desenvolvidos sob a perspectiva de trazer inúmeros aspectos de sustentabilidade, a fim de obter tecnologias capazes de aliar eficiência com fatores econômicos, ambientais e sociais”, pontua o doutorando.
A pesquisa como um caminho para o desenvolvimento da sociedade
Mateus ingressou na UPF no mestrado do PPEng, o qual ele considera um divisor de águas em sua trajetória na pesquisa. “Meu interesse pela pesquisa surgiu antes mesmo de ingressar na graduação, mas para isso se tornar realidade eu sabia que precisava iniciar minha jornada na ciência, o que ocorreu através da iniciação científica. Minha relação com a UPF surgiu no mestrado, onde desenvolvi minha dissertação sob orientação da professora Dra. Luciane Maria Colla e agora no doutorado estou sob orientação do professor Dr. Jeferson Steffanello Piccin. Não tenho dúvidas que foram as parcerias que criei com professores e colegas do programa, além das parcerias externas, que me possibilitaram receber esse reconhecimento tão significativo para minha trajetória na carreira de cientista”, destaca.
Para o professor Dr. Jefferson Piccin, essa é uma conquista importante e muito merecida para o Mateus e para a Instituição. “Essa é a primeira vez que um jovem pesquisador da UPF conquista esse título. Desde o mestrado o Mateus já se destacava em termos de pesquisa e como ser humano e nessas situações nós professores somos facilitadores, pois o mérito é todo dele. Parabenizo a iniciativa da Fapergs em olhar para os jovens pesquisadores e valorizar essas pessoas que tanto têm a contribuir para nossa ciência”, afirma o professor.
Para Mateus, o reconhecimento no Prêmio representa muito enquanto jovem pesquisador.
“O sentimento é de gratidão a todas oportunidades que tive durante essa trajetória e as pessoas que direta ou indiretamente contribuíram para que eu visse meu nome na lista de agraciados do "Prêmio Pesquisador Gaúcho 2023" da Fapergs. Me sinto honrado em representar tantos outros jovens que, assim como eu, acreditam no poder da educação e que consideram a pesquisa como um dos caminhos para o desenvolvimento da sociedade”, finaliza.
Premiação
A premiação ocorrerá no dia 31 de outubro, às 18h30, no Salão de Convenções da Federação das Indústrias do Estado do Rio Grande do Sul (Fiergs).
Notícias relacionadas